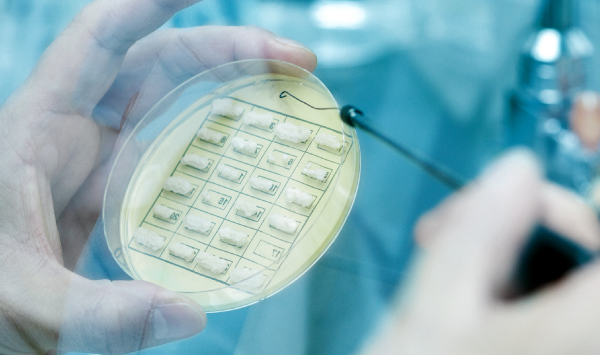

酒をつくるということ
創業からおよそ200年。
私たちはひたむきに、酒づくりと向き合い続けてきました。
その根幹を支えるのは、「水」と「米」、そして「人」。
脈々と受け継がれてきた知恵と技によって、その味わいに磨きをかけています。
創業からおよそ200年。私たちはひたむきに、酒づくりと向き合い続けてきました。その根幹を支えるのは、「水」と「米」、そして「人」。脈々と受け継がれてきた知恵と技によって、その味わいに磨きをかけています。
この地の水 この地の米
厳しい冬がもたらした多くの雪が、春になり雪解け水となって地層へ染み込み濾過され、
地下水脈となる──朝日酒造の仕込み水は、この清澄な地下水脈から汲み上げる、
新潟県内でもとりわけ硬度が低いやわらかな水です。
この特別な水は、醸造の際に穏やかな発酵を促し、
その酒はキメが細かく飲みやすい味わいとなるのです。
水とともに、酒づくりに重要なのが米の質。
米作りに理想的な気候と、信濃川などの河川によってもたらされた肥沃な土壌が、
新潟に豊かな稲穂を実らせます。
この地の水、この地の米の力が、上質な酒へとつながります。
厳しい冬がもたらした多くの雪が、春になり雪解け水となって地層へ染み込み濾過され、地下水脈となる──朝日酒造の仕込み水は、この清澄な地下水脈から汲み上げる、新潟県内でもとりわけ硬度が低いやわらかな水です。この特別な水は、醸造の際に穏やかな発酵を促し、その酒はキメが細かく飲みやすい味わいとなるのです。
水とともに、酒づくりに重要なのが米の質。米作りに理想的な気候と、信濃川などの河川によってもたらされた肥沃な土壌が、新潟に豊かな稲穂を実らせます。この地の水、この地の米の力が、上質な酒へとつながります。

杜氏の感性 研究者の閃き
越後杜氏は日本三大杜氏の一つに数えられる新潟県発祥の杜氏集団で、
淡麗辛口の酒を得意とすることで知られています。
その中でも「越路杜氏」は、越路地域の雪深い気候と清らかな水を背景に、
繊細な酒造技術を育んできました。
杜氏の知恵と技、培ってきた経験は、身体に刻み込まれた知見そのものです。
朝日酒造ではその感覚を、生産管理のプロフェッショナルがデータで捉え、
現場で連携して酒づくりを進めています。
加えて、研究センターを設置し、酒づくりにまつわる基礎研究を進めるとともに、
外部専門機関との共同研究や学術発表など、次世代へつなげる取り組みを行っています。
代々の叡智が伝承された「人の感覚」。それらを永く継承可能にする「データ化と解析」。
さらに酒づくりの可能性を拓く「深化と進化のための研究」。
それぞれが互いに知見を持ち寄ることで、より高みを目指す。
その融合こそが、私たちの理想とする酒づくりであると信じています。
越後杜氏は日本三大杜氏の一つに数えられる新潟県発祥の杜氏集団で、淡麗辛口の酒を得意とすることで知られています。その中でも「越路杜氏」は、越路地域の雪深い気候と清らかな水を背景に、繊細な酒造技術を育んできました。杜氏の知恵と技、培ってきた経験は、身体に刻み込まれた知見そのものです。朝日酒造ではその感覚を、生産管理のプロフェッショナルがデータで捉え、現場で連携して酒づくりを進めています。加えて、研究センターを設置し、酒づくりにまつわる基礎研究を進めるとともに、外部専門機関との共同研究や学術発表など、次世代へつなげる取り組みを行っています。代々の叡智が伝承された「人の感覚」。それらを永く継承可能にする「データ化と解析」。さらに酒づくりの可能性を拓く「深化と進化のための研究」。それぞれが互いに知見を持ち寄ることで、より高みを目指す。その融合こそが、私たちの理想とする酒づくりであると信じています。


世界基準のプロセスマネジメント
私たちは、2009年に「ISO9001」認証、
2019年には「ISO 9001-HACCP」の認証を取得しました。
おいしさへのこだわりだけに留まらない、
徹底した衛生・安全・工程管理を行っています。
この世界基準の品質・プロセスマネジメントにより、
継続して高品質の商品をお届けできるよう努めています。

おいしさへのこだわりだけに留まらない、徹底した衛生・安全・工程管理を行っています。この世界基準の品質・プロセスマネジメントにより、継続して高品質の商品をお届けできるよう努めています。